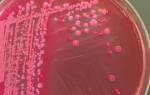

За несколько последних десятилетий специалисты отметили, что количество хронических болезней дыхательной системы увеличилось. Самыми распространёнными из них считают хронический бронхит (сокращенно ХБ) и хроническую обструктивную болезнь лёгких (аббревиатура ХОБЛ).
В патогенезе этих болезней происходит процесс воспалительного поражения бронхиального дерева, которое часто обусловлено продолжительным раздражением вирусами и бактериями, которые приводят к затяжным респираторным заболеваниям.
Поскольку в случаях с обострениями заболеваний дыхательных путей возникают проблемы с удалением гнойных мокрот, возникает необходимость назначения специальных препаратов с усиленным муколитическим и антибактериальным действием. Исходя из этого специалисты разработали лекарственное средство с комбинированным эффектом: тиамфеникол глицинат ацетилцистеина. Он объединял в себе универсальные свойства муколитика, играющего роль антиоксиданта и антибиотик с широким спектром действия.
Описание препарата
Тиамфеникол относят к группе амфениколов. Употребляют в качестве метил-сульфонильного аналога хлорамфеникола. Схож с ним по активности, тиамфеникол отличается от хлорамфеникола большим уровнем эффективности антибактериального действия, менее гепато- и миелотоксичен. Хотя он также не настолько активен, как некоторые из защищённых пенициллинов, он хорошо реагирует на наличие большинства штаммов, которые часто являются устойчивыми к широко распространённым антибиотикам.

- действующие вещества достигают непосредственного места заражения;
- повышаются концентрации препаратов в нужных органах с низкими его дозами;
- минимум побочных эффектов;
- предотвращение отрицательной реакции желудка и кишечника;
- минимизация взаимодействия лекарств.
Фармакологические свойства
Тиамфеникол является синтетическим антиюиотиком, представляющим группу амфениколов, имеющих широкий спектр действия. Этот препарат нарушает процесс синтеза белка в бактериальных клетках. К действию тиамфеникола чувствительны:
- стафилококки;
- стрептококи (учитывая и пневмококки);
- Corynebacterium diphtheriae;
- Haemophilus influenzae;
- Bordetella pertussis;
- Yersinia pestis;
- Bacteroides spp.;
- Brucella spp.;
- сальмонеллы;
- шигелы;
- Escherichia coli;
- нейссерии;
- клостридии;
- листерии.
Тиамфеникол принято применять исключительно внутримышечно или местно:
- промывание пазух;
- проведение аэрозольных ингаляций и эндобронхиальных инстилляций;
- закапывание в уши и нос.
Вещество тиамфеникола с большой скоростью распространяется по организму, накапливаясь в органах дыхательной системы. Когда он попадает в организм через ингаляции, всего за минуту концентрация препарата в крови становится такой же, как если бы его применяли парентерально. Тиамфеникол достигает своей максимальной концентрации в крови пациента через 15 минут после поступления в организм. Он способен пройти плацентарный барьер и всегда попадает в грудное молоко. Проходит метаболизацию в печени, выводится по большей чати с мочой, частично также с желчью и калом.
Показания к применению
Тиамценикол принимают при заболеваниях, которые причиняют чувствительные к нему микроорганизмы. Речь идёт о таких болезнях:
- бронхитах;
- пневмонии;
- синуситах;
- отитах;
- бронхоэктатической болезни;
- муковисцидоза;
- коклюша;
- абсцессе легких;
- подготовке к инструментальному обследованию бронхолегочной системы.
Побочные действия
При использовании этого лекарства могут возникнуть некоторые проблемы из следующего списка:
- лейкопения;
- тромбоцитопения;
- анемия;
- бронхоспазм;
- аллергическая реакция;
- стоматит;
- ринит;
- раздражение дыхательных путей;
- рефлекторный кашель при ингаляционном введении.
Однако такие ситуации возникают намного реже по отношению к применению хлорамфеникола. Помимо прочего, довольно серьезные осложнения, типа аппластической анемии или «серого синдрома» не случаются вовсе, а что до других, более мелких проблем, то они происходят намного реже.
Противопоказания
Применение тиамфеникола противопоказано при обнаружении повышенного уровня чувствительности к препарату, осложняющейся легочным кровотечением, бронхиальной астмой, язвенной болезнью с кровотечением, а также в случае тяжелого заболевания почек и печени. Если пациентка — беременная или кормящая мама, то применение препарата проводят весьма осторожно и под регулярным наблюдением врача.
Использование в ветеринарии
Тиамфеникол применяют в ветеринарии. Выпускают его для этого во флаконах по 100 мл двадцатипроцентного раствора, для лечения инфекций крупного рогатого скота и свиней, спровоцированных чувствительными к препарату возбудителями. Применяют его парентеральным способом.
Результаты проведенных исследований
Краткая информация: препарат под названием тиамфеникол глицинат ацетилцистеинат — это антибиотик, который обладает уникальным свойством. Это свойство — возможность введения в организм больного человека аэрозольным образом. Таким образом, находясь в дыхательных путях он проходит гидролиз и расщепляется на тиамфеникол (TAF) + N-ацетилцистеин (NAC).
Вторая составляющая обладает специфическими муколитическими свойствами, что значительно облегчит проникновение первой составляющей в область нижних дыхательных путей и внутрипросветных пулов слизи. Таким образом, бактерии, являющиеся возбудителями респираторных заболеваний (и которые часто недоступны для лекарств, попадающих в организм другим ходом), очутятся в запертой ловушке, откуда нет выхода.
Согласно полученным результатам проведенных исследований, TAF способен подавить большее количество бактериальный инфекционных возбудителей, хотя некоторые из их штаммов часто намного более устойчивые для пенициллина или эритромицина. Препарат переносится отлично. На данный момент возобновляется интерес к тому, чтобы использовать этот вид антибиотика для лечения инфекций дыхательных путей.
Разновидности терапии с применением антибиотиков против бактерий и вирусов, причиняющих респираторные заболевания, должна быть настолько обширной, чтобы включать некоторые из следующих микроорганизмов:
- S.pneumoniae;
- Haemophilus influenzae;
- Moraxella catarrhalis;
- Legionella pneumoniae;
- Chlamydia pneumoniae;
- Mycoplasma pneumoniae.
Некоторые представители этого списка обладают значительно повышенным уровнем резистентности к большинству разных широко распространенных антибиотиков (особенно когда речь идет о беталактамных и макролидах). Исходя из этого многие давно используемые лекарства, наподобие TAF, необходимо пересмотреть заново, с точки зрения другого подхода в их применении. Об этом много говорили во время круглого стола, который был организован в рамках третьего Международного симпозиума Европейского общества по вопросам клинической микробиологии и инфекционных заболеваний, который произошёл в 2000 году с 5 по 8 ноября, председателем которого был профессор Дж. Скито.
Выводы
В первую очередь стоит отметить, что тиамфеникол действует в широком спектре в борьбе против высокого уровня активности бактерий. Несмотря на то что он немного менее активен, чем некоторые из защищенных пенициллинов по процессу взаимодействия с Streptococcus pneumoniae, он проявляет себя довольно активно, когда речь идёт о куче штаммов, которые обычно очень устойчивы к представителям бета-лактамных антибиотиков.
Помимо этого, он на удовлетворительном уровне способен покрыть целый список некоторых внутриклеточных возбудителей, типа легионеллы, и, кроме того, активен по отношению к штаммам S.Аureus и Staphylococcus aureus VISA.
Очередным в списке преимуществ тиамфеникола стоит низкий тип сывороточно-протеиновой связи, и в итоге высокий уровень биологической доступности и высокий показатель коэффициента проникновения в легочные ткани. Другое преимущество заключается в уникальности этого препарата среди других представителей класса хлорамфениколов, которое заключается в отсутствии гематологической токсичности. Все вышеперечисленные пункты позволили ведущему стола, вышеупомянутому Грасси, прийти к выводу о значимости тиамфеникола среди списка антибиотиков, которым отдают предпочтение в первую очередь.
В конце стоит упомянуть о поступлении новой информации. FDA приняла решение исследовать инсулин в аэрозолях для пациентов, болеющих еще и сахарным диабетом. Именно аэрозольный способ введения мог бы стать наилучшим путем поступления лекарств в их организм. Это могло бы позволить избежать целого списка неприятностей, с которыми связано внутримышечное введение препаратов, с чем чаще всего приходится сталкиваться при использовании инсулина. На данный момент тиамфеникол остается единственным видом антибиотиков, который можно ввести аэрозольным способом.
Частые вопросы
Как действует тиамфеникол?
Тиамфеникол действует как бактериостатический антибиотик, то есть он препятствует размножению бактерий, но не уничтожает их полностью.
Какие инфекции можно лечить тиамфениколом?
Тиамфеникол широко используется для лечения различных инфекций, включая респираторные инфекции, инфекции мочевыводящих путей, инфекции кожи и мягких тканей, а также определенные виды менингита.
Какие побочные эффекты может вызвать тиамфеникол?
Побочные эффекты тиамфеникола могут включать аллергические реакции, нарушение кроветворения, диарею, тошноту и рвоту. В редких случаях может развиться серьезное побочное действие – апластическая анемия.
Полезные советы
СОВЕТ №1
Перед началом приема тиамфеникола обязательно проконсультируйтесь с врачом. Только специалист сможет определить необходимую дозировку и продолжительность лечения, исходя из вашего состояния здоровья и особенностей организма.
СОВЕТ №2
Следуйте инструкции по применению тиамфеникола. Не превышайте рекомендуемую дозу и не прерывайте курс лечения без указания врача. Это поможет избежать возникновения побочных эффектов и обеспечит максимальную эффективность лекарства.
СОВЕТ №3
Избегайте одновременного приема тиамфеникола с алкоголем. Взаимодействие этих веществ может привести к серьезным побочным эффектам, включая тошноту, рвоту, головокружение и нарушение функций печени.